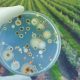
La revolución biológica en los campos de America Latina será el foco de próximo Congreso de Redagrícola

La revolución biológica en los campos de America Latina será el foco de próximo Congreso de Redagrícola
Con presencia de algunos de los principales expertos globales, Redagrícola realiza la segunda edición de su encuentro internacional de bioestimulantes y biocontrol. El evento de dos días se realiza en un mmomento en que la región es en donde más crece el uso de estos insumos agrícolas a nivel global.
Equipo Redagrícola
¿Cómo se pueden usar bioestimulantes para reemplazar a los escasos y caros fertilizantes tradicionales? ¿Cómo puede el silicio ayudar a reducir el estrés abiótico en las plantas? ¿Cuáles son las nuevas tendencias en el control biológico de plagas y enfermedades? Estos son solo algunos de las preguntas que encontrarán profundas respuestas en el 2° Congreso Bioestimulantes Latam & Biocontrol que realizará RedAgrícola a fines de este mes.
Este gran encuentro internacional se realizará los días 28 y 29 de septiembre en Lima, en el reconocido Hotel Westin, en el barrio de San Isidro. En el evento se realizarán 40 charlas y paneles en dos salones paralelos, con cientificos y expertos que son referentes en el área de los bioinsumos a nivel global.
Revise más información del Congreso y su programa haciendo clic aquí.
“América Latina es la región del mundo donde más crece el uso de insumos biológicos para la agricultura, por lo que es un lugar ideal para conocer las grandes tendencias e innovaciones que ocurren esta área”, dice Patricio Trebilcock, director y fundador de Redagrícola. “Los bioinsumos se han vuelto una pieza clave para una agricultura que no solo se preocupa por la calidad del producto, sino que también en cómo se produce; la necesidad de adoptar estrategias más sustentables los transforman en un componente esencial de las estrategias agronómicas que predominarán en los años que vienen”.
Un estudio reciente de DunhammTrimmer proyecta que, en el año 2025 y solo en los segmentos de biocontrol, América Latina tendrá un mercado cercano a los US$ 2.000 millones. Esto, con una tasa de crecimiento que promediará 17,4% anual durante la actual década. Se trata de la región con la mayor velocidad de expansión del planeta, según el estudio de la destacada firma de investigación de mercado.
Entre los participantes de este 2° Congreso de Bioestimulantes Latam & Biocontrol están el destacado académico estadounidense Dr. Patrick Brown, de la Universidad de California en Davis, el investigador español Dr. Enrique Monte Vázquez, de la Universidad de Salamanca y referente global en el área de trichoderma, el experto brasileño Dr. Wagner Bettiol, de Embrapa y reconocido referente en los bioinsumos en Brasil, así como la científica colombiana Dra. Alba Marina Cotes, principal impulsora de los bioinsumos en su país.

Junto a ellos estarán 36 expertos de Europa, Estados Unidos, América Latina y Perú, en cuyas presentaciones abordarán distintas áreas relacionados a los bioinsumos:
-Bioestimulantes y su efecto en nutrición y condición del suelo
-Manejo de estrés biótico y abiótico
-Desarrollo y manejo fenológico de las plantas
-Nuevas tendencias en el biocontrol
Además, se profundizará en las principales tendencias en el mercado de los bioestimulantes y biocontroladores en América Latina y el mundo.
El Congreso tendrá la opción de participar de manera presencial, así como online. Inscríbase y participe en la modalidad que prefiera haciendo clic aquí.
Este encuentro a realizarse en la capital de Perú, uno de los países más dinámicos del mundo en agropexportaciones, forma parte de una serie de iniciativas que ha llevado a cabo Redagrícola para difundir el conocimiento y las innovaciones en materia de bioinsumos. A inicios de año lanzó el proyecto Biologicals Latam, un newsletter y sitio web en español e inglés, con reportajes y noticias sobre el desarrollo de biológicos en el mundo, con un toque latinoamericano.
Además, ha realizado las Series Online de Bioestimulantes y Biocontrol, conferencias por streaming que reúne a algunos de los principales cerebros globales en el área de bioinsumos. Durante el año se han realizado cinco de estos encuentros, con temas enfocados a bioestimulantes como nutrientes, innovaciones en biocontrol, bioestimulantes en base a microorganismos, estrategias de suelo vivo y opciones biológicas para el estrés abiótico.
Conozca más de las Series de Bioestimulante y Biocontrol haciendo clic aquí.







